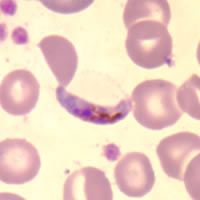
malaria_P_falciparum

Plasmodium falciparum
What causes Malaria?
A tiny singled-celled creature called Plasmodium. In order to complete its life-cycle, Plasmodium must live both in an insect host - specifically the female Anopheles mosquito - and a human host. If an Plasmodium infected mosquito bites a human, the parasite passes into the person's bloodstream and heads straight for the liver. There it invades the liver-cells and multiplies. Two weeks later, the Plasmodium bursts out of the liver and spills into the blood-stream where it begins a repeated cycle of invading red blood cells, multiplying still more and then bursting out of the cells and re-invading more red blood cells. At this point the infected person experiences symptoms of malaria such as fever, vomiting and headaches followed by chills. If left untreated, they may develop anaemia - and in some cases, the patient goes into a coma and will probably die. This is known as Cerebral Malaria.
Types of Malaria parasite in Humans
There are 4 different species of Plasmodium which cause malaria in humans but the 2 most important are Plasmodium falciparum - which is the most severe form - and Plasmodium vivax. Plasmodium falciparum is the predominant form of the malaria parasite in Africa whereas Plasmodium vivax is much more common in Asia and South America. The other two forms of the parasite are called Plasmodium ovale and Plasmodium malaria.
P. falciparum.
This species was originally sensitive to chloroquine, however, strains resistant to this and other antimalarial drugs are now commonplace. Because the parasite is able to multiply very rapidly and sequester within the microvasculature, a life threatening illness may develop in a very short space of time.
Uncomplicated malaria (where patients can take oral therapy) can be treated with one of three regimens:
Choice of regimen is based on:
In uncomplicated cases in which nausea and vomiting preclude oral therapy, quinine dyhidrochloride 10 mg salt/kg base can be given I.V. in 5% w/v dextrose or normal saline as a 4-hour infusion 8-hourly until the patient can take medication by mouth.
Severe malaria. (where patients have coma, jaundice, renal failure, hypoglycaemia, acidosis, severe anaemia, high parasite count, hyperpyrexia) is ideally treated in an intensive care or high dependency unit where patients can be monitored closely both clinically and biochemically. Intravenous quinine is the treatment of choice but rapid injection can lead to hypotension, dysrhythmias and death.
In patients who have not received quinine in the previous 48 hours, one of two regimens can be used:
Electrocardiographic monitoring can be done if available but is not essential unless additional cardiac risks are present.
Where patients have received quinine within the previous 24 hours, give quinine dihydrochloride 10 mg salt/kg base I.V. in 5% w/v dextrose or normal saline as 4-hour infusions, 8-hourly. Hypoglycaemia may occur in patients with severe malaria particularly in patients treated with Quinine and careful monitoring is required. Steroids should not be used in patients with severe malaria.
P. vivax.
Most strains of P. vivax are still sensitive to chloroquine although some chloroquine resistant strains have been reported in Papua New Guinea, Indonesia, Thailand and India. This drug will clear the erythrocyte stages of the parasite but it has no effect on the exo-erythrocytic liver stage and a course of primaquine (an 8-amino-quinoline) is required for radical cure. The Chesson strain of P. vivax found in New Guinea shows some resistance to primaquine and an increased dose of primaquine is required. If primaquine is not given, the patient may suffer a relapse which will occur weeks or months after the original attack.
Adult treatment.
Based on Chloroquine tablets containing 150mg base.
Day 1 4 tablets (600mg base) or 10 mg/kg first dose.
2 tablets (300mg base) or 5 mg/kg 6-8 hours later. Day 2 2 tablets (300mg base) or 5 mg/kg. Day 3 2 tablets (300mg base) or 5 mg/kg Next 14 days primaquine 2 tablets (each tablet contains 7.5mg base daily with food ).
The primaquine is preferably started after the chloroquine. When the infection is acquired in New Guinea, 3 tablets of primaquine (22.5mg base) should be given daily for 14 days. In the case of a relapse repeat both chloroquine and primaquine treatment. Up to three relapses may occur before the parasite is finally eliminated. Unfortunately there is no other effective treatment. Etaquine is a newly developed long-acting, potent primaquine-like drug which may be available soon for radical cure.
Patients should have their G6PD status checked before primaquine is prescribed. Those with G6PD deficiency may undergo haemolysis if given a daily dose of primaquine and it is recommended that these patients be given 30-45mg once a week for 8 weeks.
Malarone TM may also be used to treat P. vivax malaria but a course of primaquine will still be required to eliminate liver forms.
P. malariae, P. ovale.
Treatment for the eradication of these two strains of malaria is the same as that for P. vivax except it is not necessary to give primaquine to those patients with P. malariae
Artemisinin has been used for many years by the Chinese as a traditional treatment for fever and malaria. It is a sesquiterpene lactone derived from Artemisia annua. Because it is being increasingly used in a number of countries and is both cheap and effective it was decided to include treatment schedules here. However, it is not yet licensed for use in Australia, North America or Europe. Its main value at present is in the treatment of multi drug resistant falciparum malaria. If artemisinin is used to treat vivax malaria it should be accompanied by a course of primaquine. Unless used with a second antimalarial as described below there is likely to be a high recrudescent rate. Side effects have been reported but these are comparatively rare and seldom severe. It is recommended only for treatment not for prophylaxis.
Artemisinin (500mg tablets): give 10-20 mg/kg on day 1 (500-1,000 mg) orally then 500mg for 4 days. Then give mefloquine 15mg base/kg or split dose 25mg base/kg.
Artemisinin (200 mg suppositories): for severe malaria 600-1200mg stat, 400-600mg after 4 hours then 400-800mg twice daily for 3 days. Give mefloquine as above.
Artesunate (50 & 60 mg vials for intravenous use): for severe malaria 120mg I.V. stat. 60 mg at 4, 24 and 48 hours, 50-60 mg on days 3-5. Give mefloquine as above.
Dihydroartemisinin (20 mg tablets): first dose 120mg then 60mg daily for 4-6 days then give mefloquine as above.
Artemeter (vials for intramuscular use ): for severe malaria 3.2 mg/kg intramuscularly stat then 1.6mg/kg twice daily for 3-7 days, Give mefloquine as above.
Caution: A recent report on the sale of artesunate in South East Asia found that 38% of the artesunate purchased was fake (Lancet 2001;357:p1948-49). Fake artesunate can be identified by a dye test (J. Pharm Biomed Anal 2000;24: 65-70).
Malaria Parasites: